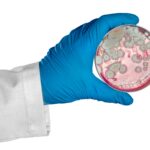
Winter Mold Impacts Air Quality

Water Damage Restoration Toronto
Get Fast water damage restoration in Toronto. Our ⭐IICRC-certified water-damage experts handle floods, burst pipes, sewage backup & repairs 24/7. ☎️ Call 647-985-2739 now to get a free quote.
Toronto’s #1 Water Damage Experts For Flooded Basements
Water damage in Toronto moves fast. Water from a burst pipe, flooded basement, roof leak, or sewage backup spreads through walls and floors and raises indoor moisture within minutes. This creates structural damage and ideal conditions for mold growth.
Our Toronto water damage restoration team responds 24/7. We extract water, track hidden moisture, dry the structure, and repair the damaged areas. We use certified equipment like moisture meters, thermal imaging, air movers, and dehumidifiers to control the problem and protect your home.
Many homeowners call after seeing standing water, hearing a leak, or smelling sewage. Others call after storms or failed plumbing. Our goal is to stop further damage, restore safety, and guide you through cleanup, drying, and repair with clear steps.
⭐ TALK TO OUR WATER DAMAGE SPECIALIST. CALL US TODAY ☎️ 647-985-2739
What Are The Main Causes of Water Damage?
Water damage in Toronto usually comes from a small set of high-risk events. Each event pushes water into building materials and raises humidity fast. These are the most common sources:
- Burst pipes. A burst pipe releases pressurized water into walls and floors and causes sudden flooding.
- Frozen pipes. Winter temperatures freeze supply lines and create pipe cracks that leak once thawed.
- leaks from supply lines, sinks, toilets, or showers feed moisture into drywall and subfloors.
- Flooded basements. Heavy rain, poor grading, or sump pump failure let groundwater enter basements.
- Roof leaks. Damaged shingles or ice dams allow water to drip into ceilings and insulation.
- Appliance overflow. Washing machines, dishwashers, and water heaters fail and spill large amounts of water.
- Sewage backup. Blocked drains or heavy rain push contaminated water into basements or lower floors.
- Foundation seepage. Hydrostatic pressure forces water through foundation cracks and slab joints.
Each cause introduces moisture that can weaken the structure and accelerate mold growth. Fast extraction and drying prevent most secondary damage.
OUR WATER DAMAGE RESTORATION SERVICES
We provide complete water damage restoration for Toronto homes and commercial spaces. Each service controls moisture, protects the structure, and prevents mold growth.
- Water extraction. Pumps and wet vac systems remove standing water from floors, basements, and affected rooms.
- Structural drying. Air movers and commercial dehumidifiers lower moisture levels in drywall, subfloors, ceilings, and insulation.
- Moisture detection. Thermal imaging and moisture meters track hidden water inside walls and building cavities.
- Sewage cleanup. Contaminated water from sewer backups is removed, disinfected, and treated for odour control.
- Odour removal. HEPA air scrubbers and filtration systems improve indoor air quality after flooding or sewage events.
- Material removal. Damaged drywall, flooring, baseboards, and insulation are removed when saturation cannot be reversed.
- Repair and rebuild. We restore damaged areas, including drywall, flooring, trim, and structural components.
- Mold removal, testing & prevention. Antimicrobial treatments and humidity control block mold from forming after water damage.
Our Toronto water damage restoration services stop active water damage, stabilize the structure, and restore safe living conditions.
WHY CHOOSE ULTIMATE MOLD CREW FOR WATER DAMAGE RESTORATION IN TORONTO
Our team handles water damage in Toronto with precision, fast response, and certified methods. Homeowners trust us because we use strong inspection tools, proven drying systems, and clear communication during urgent situations.
- Certified technicians. Our team follows IICRC standards for water extraction, structural drying, and sanitation.
- 24/7 emergency response. We respond day or night to burst pipes, basement floods, roof leaks, or sewage backups.
- Advanced equipment. Moisture meters, thermal imaging, air movers, and commercial dehumidifiers help us control damage fast.
- Full restoration service. We manage extraction, drying, cleanup, material repairs, and mold prevention in one process.
- Insurance support. We guide homeowners with documentation, photos, and estimates for insurance claims.
- Local experience. We understand Toronto homes, older basements, winter pipe issues, and storm-related flooding.
These advantages help protect your property and reduce long-term damage.
⭐ For fast water damage restoration in Toronto, contact our team now.
Toronto Water Damage Restoration Process – Step by Step
Our process follows a clear sequence to stop water, remove moisture, and restore the structure safely.
Step 1: Inspection and assessment. Moisture meters and thermal imaging identify the water source, saturation level, and affected materials.
Step 2: Water extraction. Pumps and wet vac systems remove standing water from floors, basements, and low-lying areas.
Step 3: Drying and dehumidification. Air movers and commercial dehumidifiers reduce humidity and dry walls, ceilings, and subfloors.
Step 4 – sanitization. Disinfectants and HEPA filtration remove contaminants, bacteria, and odours from the affected space.
Step 5: Material repair. Damaged drywall, insulation, flooring, and trim are removed and replaced when needed.
Step 6: Final check and mold prevention. Moisture readings confirm the structure is dry, and antimicrobial treatments prevent mold growth.
This process restores safety and reduces the risk of long-term structural damage.
TYPES OF WATER DAMAGE WE HANDLE
Our process follows a clear sequence to stop water, remove moisture, and restore the structure safely.
Different water events create different risks. We handle all forms of water damage in Toronto homes and commercial buildings.
- Basement flooding. Groundwater, storms, or sump pump failure push water into basements and foundation walls.
- Burst and frozen pipes. Winter pressure cracks supply lines and sends water into walls, ceilings, and floors.
- Roof leaks. Damaged shingles or ice dams let water seep into attics and ceiling drywall.
- Plumbing failures. Leaks from sinks, toilets, tubs, and showers saturate drywall and subfloors.
- Sewage backup. Blocked drains or heavy rain force contaminated water into lower levels.
- Appliance overflow. Washing machines, dishwashers, and water heaters release large amounts of water quickly.
- Crawl space water. Standing water under the home raises humidity and affects air quality.
- Commercial water damage. Offices, retail spaces, and industrial units can flood after storms or pipe failures.
Toronto Water Damage FAQS
What Should Homeowners Remember After Water Damage?
Water damage can cause health risks, property loss and structural problems, often faster than expected.
- Acting quickly — within 24–48 hours — is critical to prevent mold and microbial growth.
- Document damage thoroughly and notify your insurance provider early.
- Professional cleanup and restoration ensure safe, effective recovery.
- After drying and sanitation, preventive measures and periodic inspection help avoid future water‑related damage.
By following these steps systematically, homeowners can restore their home safely and reduce long-term risks from water damage and mold.
What Does Water Damage Repair Involve?
Restoration typically includes several phases, depending on the extent of damage:
Water extraction and drying — removing water, pumping out excess moisture, and drying building materials.
Structural repair — repairing or replacing damaged drywall, flooring, insulation, or ceiling materials.
Sanitization — cleaning and disinfecting all surfaces, mitigating bacterial or microbial hazards.
Mold remediation (if required) — eradicating any mold growth and treating materials to resist future growth.
Replacement of damaged items — furniture, cabinetry or appliances beyond repair.
Each project is different; cost and scope depend on severity, area affected, and materials involved.
Water Damage Repair & Restoration Cost in Toronto
The average cost of restoring water damage due to water leakage, foods or moisture buildup could be between $3.00 to $10.00 per square foot and may be around $2,800. For an average home the estimated cost to repair water damage depends on many factors.